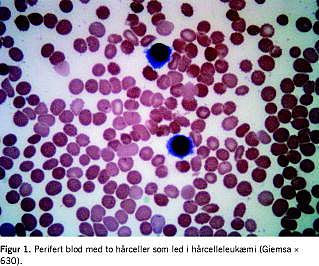

En 40-årig mand med hårcelleleukæmi (HCL) blev behandlet med en enkelt cladribinkur og opnåede partiel remission. Som forventeligt var der sygdomsprogression efter to år og fem år, hvor cladribinbehandling blev gentaget. En knoglemarvsundersøgelse efter sidste cladribinkur afslørede komplet remission (CR) med restsygdom. Det blev besluttet at konsolidere med fire serier rituximab, hvorefter der blev opnået CR, som blev konfirmeret ni måneder senere.Rituximab synes således at være et rationelt behandlingsvalg til patienter med refraktær HCL pga. præparatets signifikante aktivitet og minimale toksicitet.
Hårcelleleukæmi (HCL) er en sjælden kronisk B-celle-sygdom, som udgør 2-3% af alle leukæmier. Den kliniske tilstand domineres af recidiverende infektioner, splenomegali og pancytopeni med relativ lymfocytose af karakteristiske »hårceller«, som også findes i knoglemarven. Disse celler udtrykker pan-B-cellemarkørerne CD19, CD20, CD22, CD79a, har kraftig ekspression af CD11c, CD25, CD103 og monoklonal markering for overfladeimmunglobulin. På histologisk materiale kan HCL-cellerne påvises vha. B-cellemarkører kombineret med antistofferne DBA-44 og tartratresistent sur fosfatase (TRAP). Der er ingen karakteristiske cytogenetiske abnormiteter ved HCL.
Behandling er forbeholdt symptomatiske patienter og omfatter primært purinanaloger, mens strategien ved refraktær sygdom eller relapssygdom ikke er standardiseret. Hidtil har behandlingsmulighederne inkluderet rebehandling med purinanaloger, INF-α og splenektomi, mens der er rapporter, hvori der dokumenteres effekt ved behandling med anti-CD20-antistoffet rituximab.
I denne kasuistik præsenteres en lærerig sygehistorie, hvor komplet remission (CR) blev opnået efter rituximabbehandling hos en patient med refraktær HCL. Målet med arbejdet er at gøre opmærksom på den udvikling, der foregår i behandling af refraktær HCL.
Sygehistorie
En tidligere rask 40-årig mand med øget infektionstendens gennem et år blev indlagt med venstresidige mavesmerter. Ved en objektiv undersøgelse blev der påvist splenomegali, som ved ultralydskanning blev udmålt til 26 cm i den længste diameter. Der blev påvist pancytopeni og relativ lymfocytose med HCL-morfologi (Figur 1 ) og ekspression af CD11c, CD19, CD25 og CD 103. I knoglemarvsbiopsi og koagel blev der påvist tilsvarende forandringer.
Patienten blev behandlet med en enkelt cladribin (purinanalog)-kur og opnåede partiel remission. Som forventeligt skete der sygdomsprogression efter to år og fem år, og cladribinbehandlingen blev gentaget. Ved en knoglemarvsundersøgelse to måneder efter sidste cladribinkur blev der påvist få små infiltrater af HCL-celler. Resultatet af en flowcytometri bekræftede dette, idet der kunne påvises en monoklonal population af B-lymfocytære celler, der udgjorde 1-2% af marvens celler med kraftigt markering for CD11c, CD19, CD 20 og CD103. Herefter blev det besluttet at konsolidere med fire serier rituximab 375 mg/m2 givet med en måneds interval.
Der blev herefter opnået CR, idet hverken morfologisk, immunhistokemisk eller flowcytometrisk analyse viste tegn på rest-HCL. Resultatet blev konfirmeret ni måneder senere.
Diskussion
Anvendelse af purinanaloger har forbedret overlevelsen hos patienter med hårcelleleukæmi. Der opnås som regel langvarig remission efter en enkelt cladribinkur, og der er rapporteret om 4-5 års relapsfri overlevelse hos 70-85% af patienterne.
Relaps kan rebehandles med purinanaloger, hvorved der opnås en responsrate på 70-90%, men remissionen er kortvarig og behandlingen ledsages af hyppige bivirkninger [1]. Der foreligger nu enkelte publikationer om rituximabbehandling af patienter med behandlingsrefraktær HCL og relaps-HCL [1-5]. Thomas DA et al anvendte rituximab til behandling af 15 patienter med relaps-HCL og refraktær HCL og raporterede om en responsrate på 80%, hvoraf 53% opnåede CR [1]. Lignende resultater blev rapporteret af Hagberg H, & Lundholm L , som anvendte rituximab til behandling af 11 patienter med relaps-HCL (otte patienter) og nydiagnosticeret (tre patienter) HCL [2]. Syv ud af 11 patienter responderede (64%) med seks CR og en partiel remission. Ravandi F et al anvendte rituximab til eradikation af minimal residual disease (MRD) [3]. Tretten patienter med nydiagnosticeret HCL (11 patienter) og relaps-HCL (to patienter) blev behandlet med cladribin, efterfulgt af otte serier rituximab. Alle 13 patienter opnåede CR (100%). MRD var eradikeret hos 11 (92%) ud af 12 patienter vurderet ved anvendelse af polymerasekædereaktion og hos 12 (92%) ud af 13 patienter vurderet ved anvendelse af flowcytometri. Rituximabbehandling var veltålt bortset fra lette infusionrelaterede bivirkninger. Der blev ikke observeret øget infektionstendens, og der blev ikke registreret faldende immunglobulinkoncentrationer.
Patienten i denne rapport blev behandlet med cladribin flere gange uden at opnå CR. Tillæg af rituximab resulterede i CR, hvilket understøtter de tidligere iagttagelser af effekten af rituximab i behandlingen af hårcelleleukæmi. Rituximab synes således at være et rationelt behandlingsvalg til patienter med relaps-HCL og refraktær HCL pga. præparatets signifikante aktivitet og minimale toksicitet. Optimal dosis og behandlingsinterval er ukendt, men der anbefales som regel 375 mg pr. m2 pr. uge i 4-8 serier [1-3].
Irma Petruskevicius , Hæmatologisk Afdeling, Medicinerhuset, Mølleparkvej 4, Postboks 561, DK-9100 Aalborg E-mail: irp@rn.dk
Antaget: 6. januar 2007
Interessekonflikter: Ingen angivet
LitteraturPAN>
<ol class="Litt-list">
<li>Thomas DA, O´Brien S, Bueso-Ramos C et al. Rituximab in relapsed or refractory hairy cell leukemia. Blood 2003;102:3906-11.</li>
<li>Hagberg H, Lundholm L. Rituximab, a chimeric anti-CD20 monoclonal antibody, in the treatment of hairy cell leukemia. Br J Haematol 2001;115:609-11.</li>
<li>Ravandi F, Jorgensen JL, O´Brien SM et al. Eradication of minimal residual disease in hairy cell leukemia. Blood 2006;107:4658-62.</li>
<li>Cervetti G, Galimberti S, Andreazzolli F et al. Rituximab as treatment for minimal residual disease in hairy cell leukaemia. Eur J Haematol 2004;73:412-7.</li>
<li>Goodman GR, Bethel KJ, Saven A. Hairy cell leukemia: an update. Curr Opin Hematol 2003;10:258-66.</li>
</ol>
Summary Complete remission after Rituximab treatment in refractory hairy cell leukemia Ugeskr Læger 2008;170(26):2350. A 40-year-old man with hairy cell leukemia (HCL) was treated with Cladribin, but achieved only partial response (PR). As expected, both 2 and 5 years later the disease had progressed and the patient was therefore twice retreated with Cladribin. A bone marrow examination after the last Cladribin course showed complete response with residual disease (CR-RD). The patient received consolidation therapy with Rituximab, achieved complete response (CR) and was still in CR 9 months later. Rituximab is a good treatment option for patients with refractory HCL because of its significant activity and minimal toxicity.